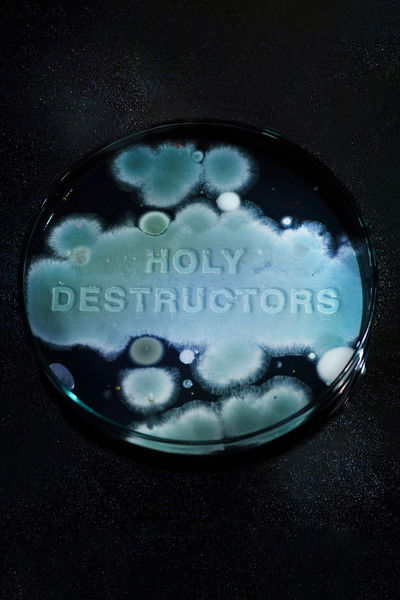
Poster do Filme Biodestruktoriai

Produtora To Be Continued

7.1
Onoda - 10 Mil Noites Na Selva
7.0
Y'a pire ailleurs
6.6
Les Dents du bonheur
5.9
O Brilho do Diamante Secreto 6.0
Era di marzo
6.0
Dreamers
5.9
La Macchinazione
5.7
Todos os Deuses do Céu
4.6
Sol Ardente

Macaronis
Bolt
Vintage
La Métamorphose
Sauvageon
Dieu reconnaîtra les siens